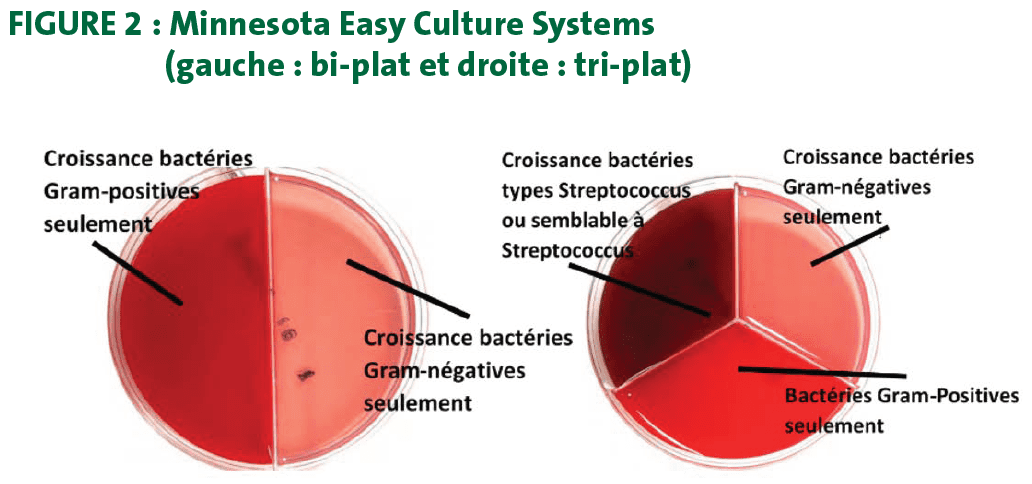

Les problèmes de mammites sont souvent caractérisés par une diminution de la qualité du lait produit par la vache affectée. Cette diminution peut être passagère ou au contraire perdurer et possiblement engendrer des problèmes pouvant mener à la perte de l’animal en question. Les coûts associés aux mammites peuvent varier d’un cas à l’autre. L’estimation du total des coûts directs est de 277 $ par mammite clinique (Aghamohammadi et al. 2018). Ceci inclut le coût de traitement, la perte en lait, le lait jeté pendant le traitement et le coût de réforme. Le coût des mammites subclinique, c’est-à-dire non traitées ou sans symptômes graves, est quant à lui supérieur à celui des mammites cliniques (370 $/cas vs 277 $/cas) (Aghamohammadi et al. 2018). Cela est principalement dû aux pertes de lait, à la baisse de la qualité du lait et à la réforme.
Chaque cas nécessite une évaluation qui est souvent subjective, puisque la première méthode d’évaluation est très souvent visuelle. Cette évaluation visuelle peut se traduire par trois facteurs d’observation.
Les choix incluent :
- Apparance et texture du lait
- État visuel de la glande mammaire
- État de santé générale de la vache (fièvre, perte d’appétit, etc.)

L’évaluation de ces trois critères permet de déterminer quel est le stade de la mammite. La gradation des mammites permet non seulement d’instaurer des protocoles de détection, mais aussi des protocoles d’identification du type de mammite. Cette identification permet de déterminer la nécessité d’un traitement et éclaire sur le choix de celui-ci. Par exemple, la Figure 2 représente un système permettant l’identification à la ferme, en 18 à 24 h, de bactéries Gram-négatives ou Gram-positives (gauche) ou encore d’identifier les bactéries de types Streptococcus en plus des deux types de Gram (droite).
Une étude de Lago (2011) a démontré que l’utilisation du « Minnesota Easy Culture System bi-plate » avant le traitement a permis de diminuer de moitié l’utilisation d’antibiotiques et de réduire le temps de retrait du lait d’une journée. À la suite des résultats de la culture bactérienne, la décision de traiter ou non était prise (traitement si Gram-positives présentes). Ces résultats ont été obtenus sans différences significatives dans le temps nécessaire à la complétion du traitement, sans augmenter le risque de réinfection ou d’inefficacité du traitement 21 jours après le cas de mammite. Les coûts associés à cette pratique sont minimes en ce qui à trait l’achat des plats de tests. Le plus gros investissement est l’achat d’un incubateur, toutefois il est possible de faire cette pratique avec un incubateur d’oeuf qui peut se vendre entre 60 et 100 $. Quant aux plats de pétri, il est possible de s’en procurer auprès de l’université du Minnesota pour 3 $ US, soit environ 4 $ CAD. partenariat avec votre équipe de vétérinaires pour s’assurer d’avoir une méthode de traitement le plus efficace possible. Cette pratique peut toutefois bien s’inclure dans un contexte où l’utilisation d’antibiotiques devient de plus en plus contrôlée et surveillée.